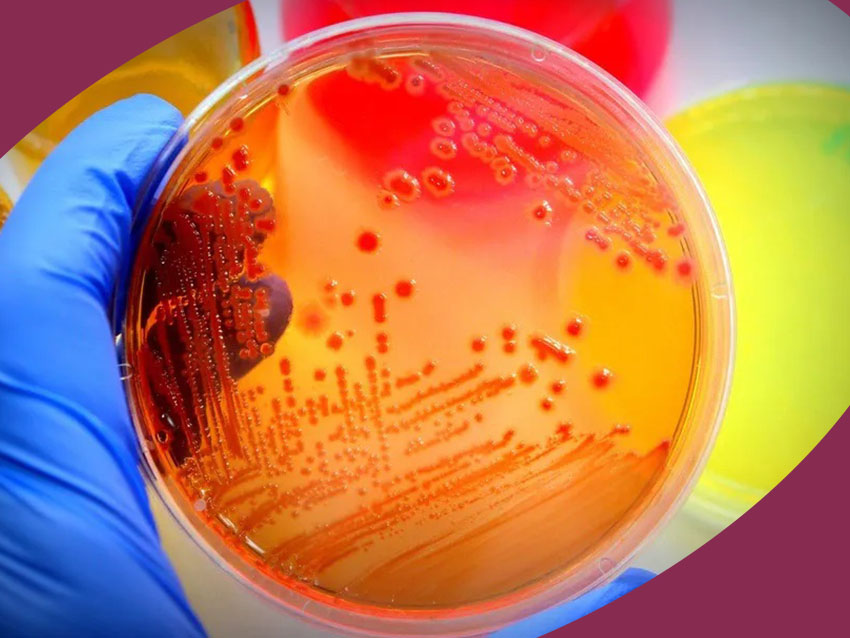

Servicios

CAPACITACIÓN ESPERMÁTICA
Nos permite diagnosticar el porcentaje de recuperación espermática necesaria para una Inseminación artificial.

COAGULACIÓN
Tiempo de Trombina,Tiempo de Protrombina, Tiempo parcial de Tromboplastina, INR, Dímero D, Tiempo de coagulación, Tiempo de sangrado, Ac. Lúpico, Factores de la coagulación y Fibrinógeno.

ESPERMOGRAMA
Es el examen diagnóstico más importante para el estudio de la fertilidad masculina.

HEMATOLOGÍA
Biometría Hemática, Frotis de sangre periférica. Recuento plaquetario, Células LE, Reticulocitos, Velocidad de sedimentación globular, Grupo sanguíneo y Factor RH.

HORMONAS
Cortisol, Testosterona, Hormona Luteinizante, Hormona folículo estimulante, Estradiol, Estrógenos totales, Progesterona, Prolactina, TSH, T4 Total, T4 Libre, T3 Total, T3 Libre, Acth, Hormona del Crecimiento (HC), Perfil ginecológico, Perfil Hormonal, Perfil Tiroideo y Perfil de Hirsutismo.

INMUNOLOGÍA 1
Reacciones Febriles, Antiestreptolisina O, Factor Reumatoide, Proteína C Reactiva, Prueba Inmunológica de Embarazo, V.D.R.L, VIH, Hepatitis A, B y C, Helicobacter Pylori, Mononucleosis, Cuantificación De Hcg, Anticuerpos Antinucleares, Ag. Carcinoembrionario.

INMUNOLOGÍA 2
Ca 15-3, Ca 125, Antigeno Prostático Específico Total, Antígeno Prostático Específico Libre, Rast Alimenticio, Rast Inhalatorio, Torch Igg E Igm, Ige Total, Panel de Inmunoglobulinas, Cariotipo con Fotografías, Prueba de paternidad por ADN, Péptido cíclico citrulinado, Niveles séricos de carbamazepina, Niveles séricos de ácido valproico, Litio, PCR y Alcohol en saliva.
MICROBIOLOGÍA
Cultivos Anaerobios, Cultivo Micológico, Hemocultivo, Cultivo de Alimentos, Cultivos Generales, Urocultivo, Coprocultivo, Cultivo Faríngeo, Cultivo Nasal, Cultivo Ótico, Cultivo Oftálmico, Cultivo de Lesiones, Cultivo de Secreciones, Cultivo de Expectoración, Cultivo Vaginal, Cultivo de Espermatozoides, Cultivo Uretral, Baar, Koh y Gram.

PARASITOLOGÍA
Coproparasitoscópico, Coprológico, Helicobacter Pylori, Sangre oculta en heces (Guayaco), Azúcares reductores y no reductores, Rotavirus, Frotis de moco fecal, IAPC e Investigación de oxiuros.

PERFILES
Perfil Prenatal, Perfil Prenupcial, Perfil Preoperatorio, Perfil Lípidos, Perfil Hepático, Perfil Hormonal, Perfil De Marcadores tumorales, Perfil metabólico neonatal, Perfil Reumático, Perfil Tiroideo, Perfil Testicular, Perfil Postmenopausia, Perfil de Lupus, Perfil de Hepatitis, Perfil de Inmunoglobulinas, Perfil de Osteoporosis, Perfil de Riesgo coronario, Perfil Torch y Perfil Rast.

QUÍMICA CLÍNICA
Química sanguínea, Perfil Hepático, Perfil de Lípidos, Perfil Bioquímico, Hemoglobina glicosilada, Calcio, Fósforo, Magnesio, Enzimas cardiacas y Electrolitos séricos.

URIANÁLISIS
Examen general de orina, Depuración de creatinina en orina de 24 horas, Depuración de ácido úrico en orina de 24 horas, Proteínas en orina de 24 horas, Citratos y oxalatos, Glucosa en orina, Antidoping, Prueba de embarazo, Cobre, Cortisol, Electroforesis de proteínas urinarias, Electrolitos urinarios, Fósforo, Microalbuminuria, Microglobulina, Nicotina y Osmolaridad en orina de 24 horas.

PRUEBAS DE PATERNIDAD POR ADN
Entre otras pruebas genéticas.